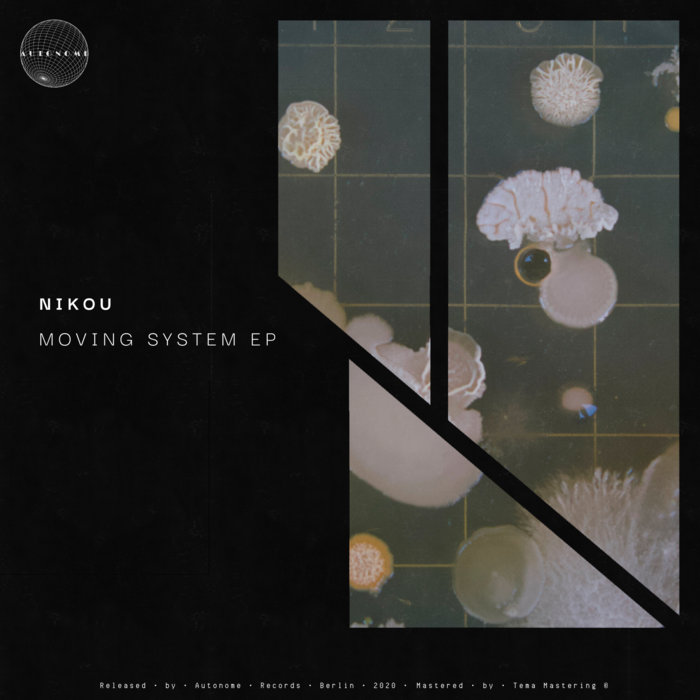

fly birds mix cut remix
fly birds mix cut remix probz mr hardwell birds fly remix
probz mr hardwell birds fly remix birds fly w&w remix 1
birds fly w&w remix 1 Hardwell feat Mr Probz Birds Fly W&W Remix Remake YouTube
Hardwell feat Mr Probz Birds Fly W&W Remix Remake YouTube Hardwell feat Mr Probz Birds Fly W&W Remix & Bastian Edit YouTube
Hardwell feat Mr Probz Birds Fly W&W Remix & Bastian Edit YouTube hardwell probz fly birds mr feat remix
hardwell probz fly birds mr feat remix remix backjack storm fly birds edge hardwell bro enjoy
remix backjack storm fly birds edge hardwell bro enjoy Hardwell Feat Mr Probz Birds Fly W&W Remix FL Studio Drop Remake YouTube
Hardwell Feat Mr Probz Birds Fly W&W Remix FL Studio Drop Remake YouTube hardwell probz feat fly birds mix mr remix cut festival
hardwell probz feat fly birds mix mr remix cut festival birds fly w&w remix 2
birds fly w&w remix 2 Vantagë Mash Up Birds Fly W&W Remix Vs Arcadia YouTube
Vantagë Mash Up Birds Fly W&W Remix Vs Arcadia YouTube![SoundExclusive4ever Lite: Birds Fly feat Mr Probz [ W&W Remix Edit] Hardwell Single](https://2.bp.blogspot.com/-CbeqiIIL5NU/WSNYh205PCI/AAAAAAAADnA/zG-svxIaP4kCRKrNIBRY6ANP1KU9xJ74QCLcB/s250/Hardwell%2BPresents%2BRevealed%252C%2BVol.%2B6.jpg) SoundExclusive4ever Lite: Birds Fly feat Mr Probz [ W&W Remix Edit] Hardwell Single
SoundExclusive4ever Lite: Birds Fly feat Mr Probz [ W&W Remix Edit] Hardwell Single Blasterjaxx Hardwell MOTi & Jonathan Mendelsohn GITM vs Like That vs Birds Fly W&W Remix
Blasterjaxx Hardwell MOTi & Jonathan Mendelsohn GITM vs Like That vs Birds Fly W&W Remix fly birds remix probz mr hardwell feat underi
fly birds remix probz mr hardwell feat underi birds fly w&w remix 3
birds fly w&w remix 3 Hardwell vs W&W Ocarina Of Time s Gerudo Valley Hardwell Remix vs Birds Fly W&W Festival
Hardwell vs W&W Ocarina Of Time s Gerudo Valley Hardwell Remix vs Birds Fly W&W Festival hardwell birds probz fly mr remix ft esquire night
hardwell birds probz fly mr remix ft esquire night hardwell fly birds
hardwell fly birds icicle whisper scream works fly birds
icicle whisper scream works fly birds hardwell probz fly birds mr ft
hardwell probz fly birds mr ft probz mr hardwell fly birds feat remix
probz mr hardwell fly birds feat remix Birds flying high Mowe Remix YouTube
Birds flying high Mowe Remix YouTube birds fly w&w remix 4
birds fly w&w remix 4 Nightcore → Hardwell ft Mr Probz Birds Fly Daniel Domm Remix YouTube
Nightcore → Hardwell ft Mr Probz Birds Fly Daniel Domm Remix YouTube probz hardwell fly birds mr ft
probz hardwell fly birds mr ft jay remix simon mr probz hardwell feat birds fly remixes track users liked
jay remix simon mr probz hardwell feat birds fly remixes track users liked Hardwell feat Mr Probz Birds Fly iiven remix YouTube
Hardwell feat Mr Probz Birds Fly iiven remix YouTube birds fly w&w remix 5
birds fly w&w remix 5 probz mr hardwell fly birds feat remix
probz mr hardwell fly birds feat remix fly birds esquire remix night hardwell late probz mr feat
fly birds esquire remix night hardwell late probz mr feat Скачать рингтон Hardwell feat Mr Probz Birds Fly eSQUIRE Late Night Remix на звонок New
Скачать рингтон Hardwell feat Mr Probz Birds Fly eSQUIRE Late Night Remix на звонок New wich dj probz remix feat trap fly birds mr hardwell
wich dj probz remix feat trap fly birds mr hardwell probz hardwell remix fly birds mr reez feat bootlegs featuring hope
probz hardwell remix fly birds mr reez feat bootlegs featuring hope remix galantis lenno mediatrix lovin ama reddit wrabel bloodstain some legendary
remix galantis lenno mediatrix lovin ama reddit wrabel bloodstain some legendary birds fly w&w remix 6
birds fly w&w remix 6:format(jpeg):mode_rgb():quality(40)/discogs-images/R-777865-1366569377-6945.jpeg.jpg?w=300) icicle works scream whisper birds fly single discogs album
icicle works scream whisper birds fly single discogs album scream fly whisper birds mix remix why moran tony havana
scream fly whisper birds mix remix why moran tony havana Dead Birds Fly Remix YouTube
Dead Birds Fly Remix YouTube Osvaldo Fly Like Birds Clark Remix YouTube
Osvaldo Fly Like Birds Clark Remix YouTube parry hardwell remix fly birds
parry hardwell remix fly birds M4730 Birds fly Original mix YouTube
M4730 Birds fly Original mix YouTube:format(jpeg):mode_rgb():quality(40)/discogs-images/R-12734973-1540939099-5952.jpeg.jpg?w=300) scream whisper fly birds icicle works release discogs vault mixes dance format versions edit sell 2006
scream whisper fly birds icicle works release discogs vault mixes dance format versions edit sell 2006 birds fly w&w remix 7
birds fly w&w remix 7 【Progressive House】Hardwell feat Mr Probz Birds Fly Aronu Remix YouTube
【Progressive House】Hardwell feat Mr Probz Birds Fly Aronu Remix YouTube![Hardwell & Tiësto feat Andreas Moe Colors Vicetone Remix [FULL] [ The madness](https://i.pinimg.com/736x/32/25/b3/3225b377014f9310a8b0d821ff6836f4--edm-music-andreas.jpg) Hardwell & Tiësto feat Andreas Moe Colors Vicetone Remix [FULL] [ The madness
Hardwell & Tiësto feat Andreas Moe Colors Vicetone Remix [FULL] [ The madness noel flying birds gallagher taught robertson remix justin premiere fly she ransom note
noel flying birds gallagher taught robertson remix justin premiere fly she ransom note gallagher noel flying birds
gallagher noel flying birds KNOW HOW I FEEL BIRDS FLYING HIGH REMIX YouTube
KNOW HOW I FEEL BIRDS FLYING HIGH REMIX YouTube llp remix fly wet project kaynak
llp remix fly wet project kaynak![Noel Gallagher s High Flying Birds Black Star Dancing [Stu s Milky Way Remix] YouTube](https://i.ytimg.com/vi/q2_8Rln2wMA/mqdefault.jpg) Noel Gallagher s High Flying Birds Black Star Dancing [Stu s Milky Way Remix] YouTube
Noel Gallagher s High Flying Birds Black Star Dancing [Stu s Milky Way Remix] YouTube Birds Fly Thomas Newson Remix Hardwell Feat Mr Probz Shazam
Birds Fly Thomas Newson Remix Hardwell Feat Mr Probz Shazam:format(jpeg):mode_rgb():quality(40)/discogs-images/R-777865-1572278783-8219.jpeg.jpg?w=300) icicle whisper scream works fly birds discogs format single
icicle whisper scream works fly birds discogs format single Imagine Dragon Birds Fly Dj Snox Reggae Remix YouTube
Imagine Dragon Birds Fly Dj Snox Reggae Remix YouTube birds fly w&w remix 8
birds fly w&w remix 8 fly remix aeroplane oliver
fly remix aeroplane oliver Noel Gallagher s High Flying Birds: Remix Visuals Sound & Colour
Noel Gallagher s High Flying Birds: Remix Visuals Sound & Colour Fly Like A Bird Hadley Cornish Remix YouTube
Fly Like A Bird Hadley Cornish Remix YouTube rsd mexicano oasis gallagher remix noel flying disc ep birds
rsd mexicano oasis gallagher remix noel flying disc ep birds songbird crow remix fly american stuff community carrara daz poser animation animals october
songbird crow remix fly american stuff community carrara daz poser animation animals october bird santana fredo remix lil talk ft joint bring goes hard very
bird santana fredo remix lil talk ft joint bring goes hard very gallagher noel weatherall andrew flying birds tense remix stream moment heat
gallagher noel weatherall andrew flying birds tense remix stream moment heat birds fly whisper scream icicle works
birds fly whisper scream icicle works Hardwell feat Mr Probz Birds Fly eSQUIRE Late Night Remix YouTube
Hardwell feat Mr Probz Birds Fly eSQUIRE Late Night Remix YouTube This Is The Place Dense & Pika Remix by Noel Gallagher s High Flying Birds on Spotify
This Is The Place Dense & Pika Remix by Noel Gallagher s High Flying Birds on Spotify noel flying birds gallagher weatherall remix andrew dub
noel flying birds gallagher weatherall remix andrew dub birds fly w&w remix 9
birds fly w&w remix 9 birds fly w&w remix 10
birds fly w&w remix 10 lawford ryon remix birds jacob let whitesides
lawford ryon remix birds jacob let whitesides![Birds Flying High Kay Vee [ Remix] YouTube](https://i.ytimg.com/vi/9Nxon_un-fw/mqdefault.jpg) Birds Flying High Kay Vee [ Remix] YouTube
Birds Flying High Kay Vee [ Remix] YouTube:format(jpeg):mode_rgb():quality(40)/discogs-images/R-1779151-1454882588-6112.jpeg.jpg?w=300) birds whisper scream fly discogs icicle works album
birds whisper scream fly discogs icicle works album Beyond The Wizard s Sleeve s remix of Noel Gallagher s High Flying Birds
Beyond The Wizard s Sleeve s remix of Noel Gallagher s High Flying Birds birds fly w&w remix 11
birds fly w&w remix 11 birds fly w&w remix 12
birds fly w&w remix 12![BLOOM Birds That Fly Stoffo Remix [Feta Records 003] YouTube](https://i.ytimg.com/vi/Dzz6H-bezWA/mqdefault.jpg) BLOOM Birds That Fly Stoffo Remix [Feta Records 003] YouTube
BLOOM Birds That Fly Stoffo Remix [Feta Records 003] YouTube birds fly w&w remix 13
birds fly w&w remix 13:format(jpeg):mode_rgb():quality(90)/discogs-images/R-5958832-1407732785-6086.jpeg.jpg?w=300) bird fly mariah carey discogs format
bird fly mariah carey discogs format Noel Gallagher s High Flying Birds The Right Stuff 3D Remix Version 1 YouTube
Noel Gallagher s High Flying Birds The Right Stuff 3D Remix Version 1 YouTube fly birds album play
fly birds album play violent fly birds
violent fly birds:format(jpeg):mode_rgb():quality(90)/discogs-images/R-6910663-1429342807-6497.jpeg.jpg?w=300) moment heat noel flying birds gallagher limited single album rsd remixes inch record discogs release remixed weatherall andrew gallaghers
moment heat noel flying birds gallagher limited single album rsd remixes inch record discogs release remixed weatherall andrew gallaghers fly birds whisper scream situation 22t sit icicle works
fly birds whisper scream situation 22t sit icicle works Download premium vector of Birds flying over river vintage illustration ในปี 2020
Download premium vector of Birds flying over river vintage illustration ในปี 2020 flying massive attack gallagher remix noel birds hear limited naja drops aka robert stuff right
flying massive attack gallagher remix noel birds hear limited naja drops aka robert stuff right noel remixes flying birds gallagher record juno gallaghers its
noel remixes flying birds gallagher record juno gallaghers its fly bird wikia
fly bird wikia:format(jpeg):mode_rgb():quality(40)/discogs-images/R-7312242-1438625404-8762.jpeg.jpg?w=300) release discogs sell fly angel edit
release discogs sell fly angel edit noel aka flying birds link
noel aka flying birds link birds fly w&w remix 14
birds fly w&w remix 14 fly birds scream whisper beggars
fly birds scream whisper beggars fly bird tvmaze
fly bird tvmaze Mzokoloko Ft Fey & Dr Moruti Fly Away NaijaRemix
Mzokoloko Ft Fey & Dr Moruti Fly Away NaijaRemix Fly Like A Bird Hadley Cornish Remix created by DJ Platinum Hand & DJ Platinum Hand Popular
Fly Like A Bird Hadley Cornish Remix created by DJ Platinum Hand & DJ Platinum Hand Popular noel flying birds gallagher remix unkle nme doherty pete radiohead queen stories week band gig pleased debut recent were come
noel flying birds gallagher remix unkle nme doherty pete radiohead queen stories week band gig pleased debut recent were come Birds Fly South Ale Project Home Facebook
Birds Fly South Ale Project Home Facebook fly birds scream whisper icicle works promo double side
fly birds scream whisper icicle works promo double side Flying Bird Synthetic Love Remix Nikou Autonome Records
Flying Bird Synthetic Love Remix Nikou Autonome Records:format(jpeg):mode_rgb():quality(40)/discogs-images/R-2887446-1305745505.jpeg.jpg?w=300) flying bird release discogs project sell album edit kbps
flying bird release discogs project sell album edit kbps DMP Announces Continuation of Yaoi Manga Twittering Birds Never Fly
DMP Announces Continuation of Yaoi Manga Twittering Birds Never Fly fly bird pitto remix remixes sein till von tigerskin sonar kollektiv beatport release
fly bird pitto remix remixes sein till von tigerskin sonar kollektiv beatport release seniors fly cleared takeoff prepare rap record pair album robertson cardinals heard likely hop written hip birds fans song
seniors fly cleared takeoff prepare rap record pair album robertson cardinals heard likely hop written hip birds fans song